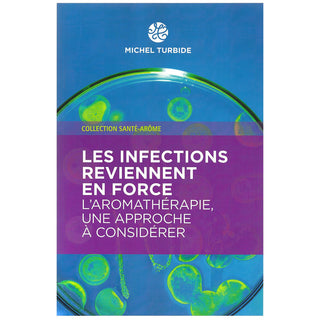

- ON SALE
- PRODUCTS
-
SHOP BY NEEDS
- SHOP BY NEEDS
-
WELLNESS
- WELLNESS
- Arthritis
- Back Pain
- Bad Breath
- Bronchitis
- Cardiovascular
- Cough & Cold
- Expectorant
- Fatigue & Exhaustion
- Headaches & Migraines
- Hemorrhoids
- Indigestion, Gas & Bloating
- Insect Bites
- Menopause, PMS & Cramps
- Muscles & Joints
- Nausea & Vomiting
- Pain Relief
- Skin Irritations
- Sprains & Strains
- Tooth Ache
- Varicose Veins
- WELL-BEING
-
COSMETIC
- COSMETIC
- Abscess & Boils
- Acne & Scars
- After-Sun Care
- Anti-Aging
- Antiseptic & Germicide
- Bruises
- Cellulite
- Combination Skin
- Dandruff & Hair Growth
- Dry Skin
- Emulsifier
- Firming
- Fungal Infections
- Hair Care
- Minor Cuts & Burns
- Moisturizing
- Nourishing & Regenerating
- Oily Skin
- Problem Skin
- Protective & Soothing
- Purifying & Antioxidant
- Sensitive skin
- THERAPEUTIC
- USAGE
- BUNDLES
- DIY RECIPES
- CONTENT
- LINKS & DOCUMENTATION
- MY SUBSCRIPTIONS
- About
- Certifications
- FAQ
- Contact Us
- Store Locator
-
Prices in CAD currency
- Register / Login